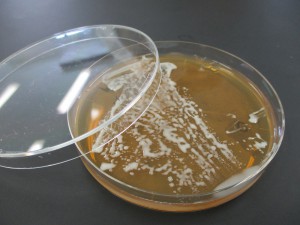

【授業のひとコマ】食物栄養学科―微生物学実験
 食物栄養学科の実験・実習をご紹介!今回は、2回生の「微生物学実験」の様子を紹介します。
食物栄養学科の実験・実習をご紹介!今回は、2回生の「微生物学実験」の様子を紹介します。
2回生春学期に実施する微生物学実験では、食中毒微生物、病原微生物の感染を防御するために、微生物を扱うための基本的操作、微生物の正しい扱い方を修得します。
今回の実験では、発酵食品から菌を単離し、観察する実験を行いました。自家製の味噌や甘酒、鮒ずしを持ってきてくれた学生さんもいましたよ!話題の乳酸菌飲料やナチュラルチーズ、納豆なども使いました!
ブルーチーズやミモレットなどヨーロッパから輸入されることの多いナチュラルチーズは世界情勢を受けて例年にない値上がり!思わぬ余波を感じた実験でした。
ブルーチーズやミモレットなどヨーロッパから輸入されることの多いナチュラルチーズは世界情勢を受けて例年にない値上がり!思わぬ余波を感じた実験でした。
シャーレに食品から植菌し、培養したものを観察、スケッチした後、顕微鏡観察も行います。
今回の実験で培養できた菌から乳酸菌を選び、さらに液体培地で培養します。菌の種類によっては培地に好き嫌いがあるのです!次回の実験では、菌の種類と培地の組み合わせの違いが、乳酸の生成に及ぼす影響を実験しますよ。

微生物を理解することは、食品加工や安全な調理、給食の運営の基礎知識となり、実践されていきます。





